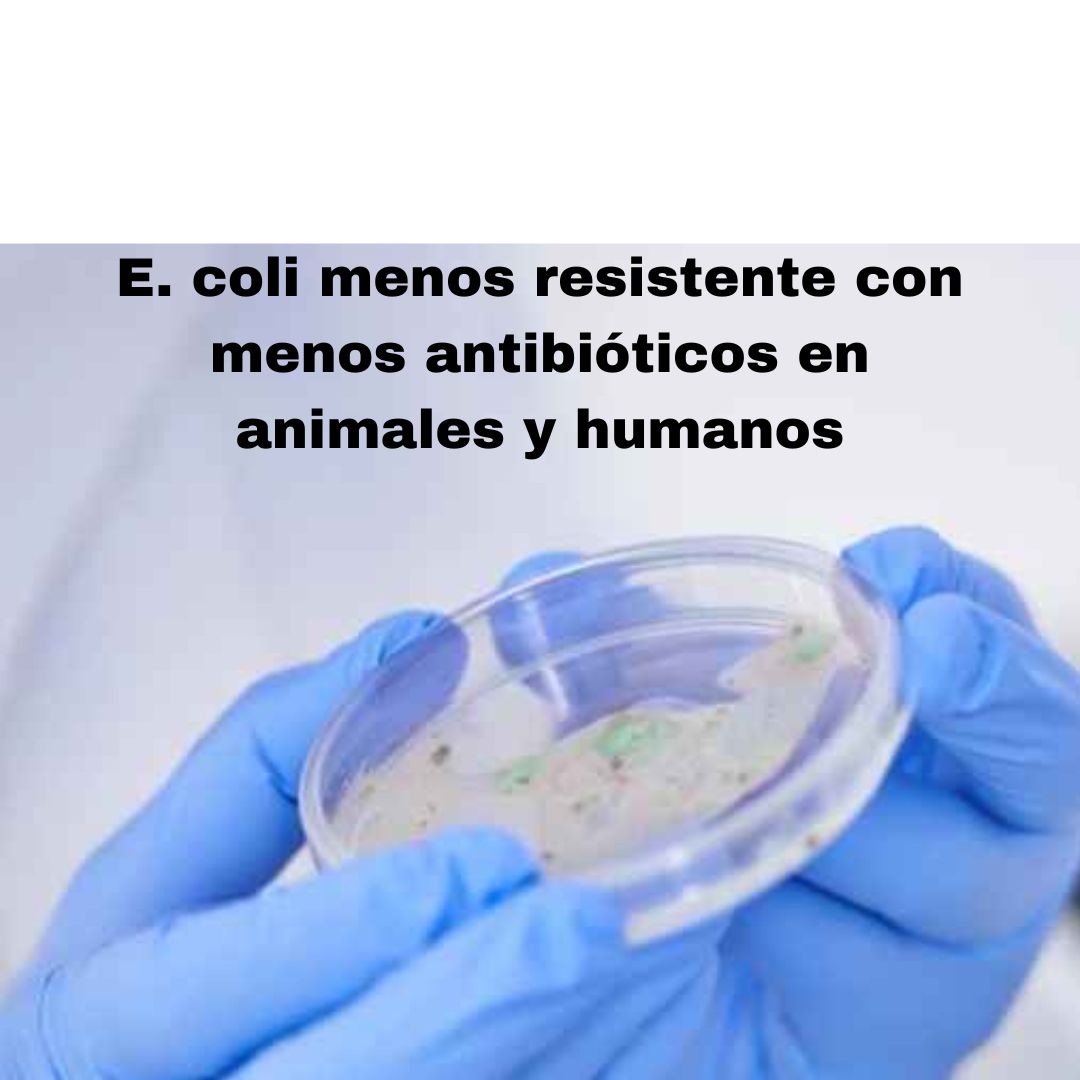

“Es imperativo aumentar los esfuerzos para reducir el consumo innecesario de antibióticos y hacer frente a la amenaza para la salud pública de la resistencia a los antimicrobianos”, comenta Andrea Ammon. TAGS: Resistencia antimicrobiana. Salud pública. Salud animal. One Health. Una Salud. E. coli
“Los países que han disminuido su consumo de antibióticos, tanto en animales como en humanos, han visto una reducción en las bacterias resistentes a los antibióticos”, destaca la Autoridad Europea de Seguridad Alimentaria (EFSA) sobre los resultados del último informe acerca del Consumo de antimicrobianos y resistencia en bacterias de humanos y animales productores de alimentos.
Publicado por EFSA, el Centro Europeo para la Prevención y el Control de las Enfermedades (ECDC) y la Agencia Europea de Medicamentos (EMA), este informe adopta un enfoque One Health, que reconoce la conexión entre la salud de las personas y los animales. Concretamente, presenta datos recopilados principalmente entre 2019 y 2021 sobre el consumo de antibióticos y la resistencia a los antimicrobianos en Europa.
Por primera vez como parte de este proyecto, las tres agencias ya mencionadas analizaron las tendencias del consumo de antimicrobianos y la RAM en Escherichia coli (E. coli), tanto de humanos como de animales productores de alimentos. También analizaron cómo estas tendencias estaban cambiando en humanos y animales productores de alimentos durante 2014-2021. “Por ejemplo, durante este período de tiempo, el consumo de antibióticos en animales productores de alimentos disminuyó un 44 %”, recalcan.
Por otra parte, el análisis realizado confirmó que las bacterias E. coli, tanto en animales como en humanos, se están volviendo menos resistentes a los antibióticos a medida que se reduce el consumo general de antibióticos. Esto demuestra, por tanto, que las tendencias preocupantes en la resistencia a los antibióticos pueden revertirse con las acciones y políticas correctas.
“Es imperativo aumentar los esfuerzos para reducir el consumo innecesario de antibióticos y hacer frente a la amenaza para la salud pública de la resistencia a los antimicrobianos. Además, el fortalecimiento de los programas de inmunización y la mejora de las prácticas de prevención y control de infecciones en las comunidades y los entornos de atención médica son esenciales para reducir las necesidades de antibióticos”, comenta Andrea Ammon, directora del ECDC.
Por su parte, Bernhard Url, director ejecutivo de la EFSA, exclama que “el uso de menos antibióticos en la producción ganadera vale la pena: en la mayoría de los países que redujeron el uso de antibióticos, observamos una disminución correspondiente en los niveles de resistencia. Esto significa que los esfuerzos nacionales funcionan. También hay que destacar el compromiso de la UE con el enfoque One Health salvaguardando la salud pública tanto animal como mundial".
Mientras tanto, Emer Cooke, director Ejecutivo de EMA, explica que “el acceso a datos fiables sobre consumo y resistencia en personas y animales marca una diferencia real en la lucha contra los antimicrobianos. A través de proyectos conjuntos como JIACRA, los países europeos obtienen ideas invaluables sobre el impacto de las medidas que toman. Esto les permite tomar medidas adicionales para promover el uso prudente de antibióticos”.
El informe también demuestra que, en humanos, el uso de grupos importantes de antibióticos, como carbapenems, cefalosporinas de tercera y cuarta generación, y quinolonas, se asocia con la resistencia a estos antibióticos en E. coli de los seres humanos.
Del mismo modo, el uso de quinolonas, polimixinas, aminopenicilinas y tetraciclinas en animales productores de alimentos se asocia a la resistencia a estos antibióticos que se produce en la bacteria E. coli en estos animales.
Además, la resistencia bacteriana en humanos puede estar relacionada con la resistencia bacteriana en animales productores de alimentos. Dos ejemplos destacados en el informe son Campylobacter jejuni y Campylobacter coli, que se pueden encontrar en animales productores de alimentos y pueden propagarse a las personas a través de los alimentos.
Conviene recalcar que, por primera vez, el código estadístico utilizado para realizar estos análisis se pone a disposición del público junto con el informe, “fomentando un mayor análisis por parte de los investigadores y otros expertos interesados”, explican.
Asimismo, desde la EFSA recuerdan que la resistencia a los antimicrobianos es una grave amenaza para la salud pública y animal. “Se estima que cada año la resistencia a los antimicrobianos causa la muerte de más de 35.000 personas en la Unión Europea y en el Espacio Económico Europeo (UE/EEE) y supone una carga significativa para los sistemas sanitarios europeos, con un coste aproximado de 11.700 millones de euros al año, según la Organización para la Cooperación y el Desarrollo Económicos (OCDE)”.
Finalmente, destacan que los resultados presentados en este informe exigen proseguir los esfuerzos para hacer frente a la resistencia a los antimicrobianos a escala nacional, de la UE y mundial. De igual modo, requieren de vigilancia armonizada del consumo de antimicrobianos y de la resistencia a los antimicrobianos y, asimismo, exigen de estudios.
Fuente: https://www.diarioveterinario.com/

No hay comentarios aún.